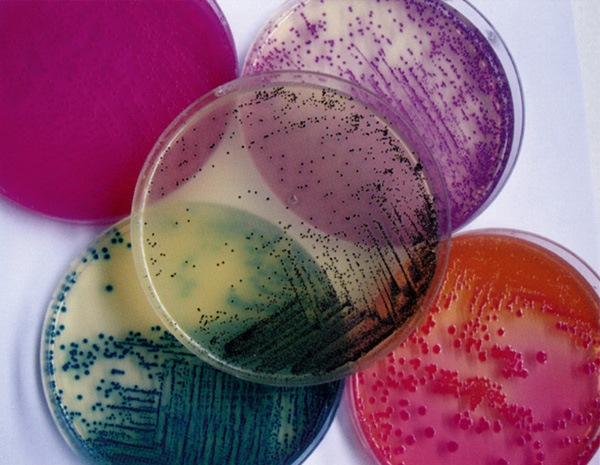
Milieu déshydraté bouillon base listeria iso 11290-1 500 g

Gauss
Milieu déshydraté bouillon base listeria iso 11290-1 500 g
Réf.
UGAP : 3658560
Réf.
Fournisseur : 777287
Réf.
Constructeur : 1120
Franco de port et d'emballage pour toutes les commandes supérieures à 80€ HT.
Produit ni repris ni échangé excepté en cas d’erreur du prestataire.
Produit ni repris ni échangé excepté en cas d’erreur du prestataire.
Points clés
Milieu d'enrichissement pour la détection et le dénombrement de Listeria dans les échantillons alimentaires et environnementaux.-ISO 11290-1
Milieu deshydrate bouillon base listeria enrichment fraser iso 11290-1 x 500 grs
Garantie
Garantie 0 Mois
Description
Milieu d'enrichissement pour la détection et le dénombrement de Listeria dans les échantillons alimentaires et environnementaux.-ISO 11290-1
Milieu deshydrate bouillon base listeria enrichment fraser iso 11290-1 x 500 grs
Caractéristiques
- Classement dans le catalogue fournisseur
- 08 - sérum - milieux - réactifs
- Marque
- CONDALAB
- Référence distributeur
- 777287
- Type d'échantillon
- tous types
- Prêt à l'emploi
- non
- Référence fabricant
- 1120
- Code à barre
- non
- Domaine de recherche
- microbiologie
- Fournisseur
- DOMINIQUE DUTSCHER S.A
- Type de produit
- bouillon
- Délai de péremption à la date de livraison
- 3 mois
- Etat
- soluble
- Soumis à carboglace
- non
- Volume
- 500 g
- Vendu par
- 500 g
- Quantité
- N/A
- Code douanier
- 38210000
- Dimensions extérieures l. x pr. x h.
- 0,08 x 0,08 x 0,19 mm
- Nomenclature IFPEN
- NA.73
- Nomenclature Nacres
- NA.73
- Nomenclature CEA
- SGP01
- Nomenclature IRSN
- 273
- Nomenclature INSERM
- NA.NA73
- Nomenclature CNRS
- NA73
- Nomenclature CHU
- 18.601
- Nomenclature DGOS
- LG10AOOO
- Reprise en cas d’erreur client
- non
- Lieu de stockage
- France - 67 Bernolsheim
- Type d’application
- culture bactérienne
- Soumis à réglementation
- non
- Lieu de fabrication
- Espagne